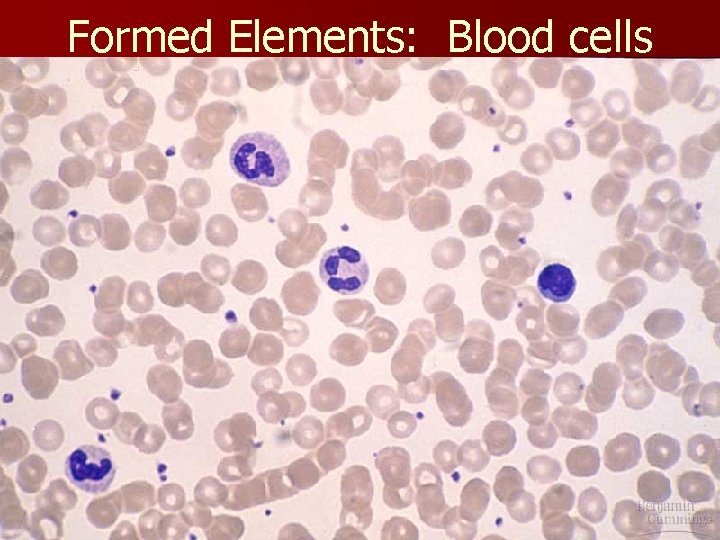
Formed Elements: Blood cells

Blood Analysis Forensic Serology and Blood Spatter Patterns

Blood Analysis Forensic Serology and Blood Spatter Patterns

Blood Fun Facts n. A connective tissue consisting of cells and cell fragments surrounded by a liquid matrix n Total volume in an adult = roughly 5 L n Makes up roughly 8% of body weight – 40% (about 2 L) loss results in death – 30% (1. 5 L) loss results in incapacitation n Red blood cells have a “life span” of roughly 120 days

Maintenance of Homeostasis n n n Transporting oxygen, nutrients, enzymes, and hormones to tissues Transporting carbon dioxide and waste products away from tissues Maintaining body temperature by transporting heat between deep tissues and the body’s surface Maintaining fluid, electrolyte, and p. H balance Protecting the body from disease-causing microorganisms, foreign substances, and tumors Preventing blood loss when blood vessels are damaged

Formed Elements: Blood cells

Erythrocytes Structure relates to Function n Small biconcave disks (thinner in center than at the edges) n Mammal’s lack nuclei n Lack mitochondria; generate ATP by anaerobic metabolism n Also, production is stimulated by low blood oxygen levels

Hemoglobin One-third of weight of a RBC n Four polypeptide chains (globins), four heme groups (each contains an iron molecule) n – Oxygen binds to heme – Carbon dioxide binds to globin n Iron is recycled when erythrocytes are broken down – Women need more iron in diet than men; why?

Sickle Cell Anemia - results from a single nucleotide polymorphism - inherited as a recessive trait

Inheritance of Sickle Cell Anemia n Normal hemoglobin is dominant n The sickle cell condition is recessive n What’s the genotype of someone who is homozygous recessive? Someone who is heterozygous? n What are the possible genotypes of their children?

Leukocytes aka – white blood cells May be used for: – Antibody production – Breakdown of bacteria, dead cells and fragments, and other debris – Regulation of inflammation

Blood Clotting

Hemophilia n An inherited defect in any step of the clotting process n Results in excessive bleeding n Most common version is a recessive sexlinked trait (on X chromosome only) XH normal male (XHY) XH x carrier female (XHXh) Xh Y

Blood Typing n Red blood cells may be covered in substances called antigens – Two types: A and B – Controlled by co-dominant alleles: IA and IB n Proteins called antibodies are floating in the plasma – Two types: anti-A and anti-B – Very specific – will bind to only one type of antigen, resulting in agglutination



Blood Type Crosses n What are the possible offspring phenotypes of the following crosses? – – – AB x O AO x AB AA x BO If a child is typed as A, and the mother is AB, is it possible for the father to be type B? n If mom is B and child is O, can dad also be B? n How could a couple have children have A, B, and AB children? n

Rh Blood Group n Named from studies on the rhesus monkey – Rh+ if Rh antigens are present – Rh- if not – Inherited as a dominant trait n Hence, someone who is “A positive” has both A and Rh antigens on their RBC’s

Rough breakdown for the US population


Is it blood? n When confronted with a stain, questions to ask include: – Is it blood? – Is it human blood? – How closely can it be associated to a particular individual?

“Presumptive” Tests for Blood n “Presumptive” necessarily – could be blood, but not – Kastle-Meyer § Hemoglobin posesses peroxidase-like activity § Turns pink – Luminol (Phenolthalein indicator) § Iron in hemoglobin catalyzes the reaction § Produces a blue-ish glow: chemoluminesence § Very sensitive – detects dilutions up to 300, 000 x

Luminol

Probabilities Different factors in the blood occur independently of each other (ABO, Rh+/-, others…) n The probability of a bloodstain having a particular combination of these factors is the product of their distribution in the population n What’s the likelihood of having PGM-2, AK 1, ADA 1, and Es. D 2? n – How about if they were also A positive? Name Types %'s PGM-1 58 PGM-2 6 PGM 2 -1 36 AK AK 1 93 AK 2 -1 7 ADA 1 90 ADA 2 -1 10 ADA 2 0. 2 Es. D 1 79 Es. D 2 -1 19 Es. D 2 2

Blood Spatter Patterns Total volume in an adult = roughly 5 L Makes up roughly 8% of body weight 40% (about 2 L) loss results in death 30% (1. 5 L) loss results in incapacitation Much thanks to www. bloodspatter. com

Uses of Blood Spatter Analysis n Reconstruction = What happened? Is the truth being told? n Shapes = distance, angle of impact n Color/consistency = age of blood stain n From gun shots = relative positions of shooter/victim

Surface Tension n Results from attractive forces between water molecules – cohesion: water attracted to water – adhesion: water attracted to other surfaces n Blood Droplets tend to be spherical (not tear-drop shaped)

n Passive Types of Blood Stains – gravity alone n Contact – wet bloody surface comes into contact with a secondary surface – transfer, smear, or wipe n Projected – due to an action greater than force of gravity – may be arterial spurt, castoff, impact, or expirated

Directionality: the tail points in the direction of travel

n Draw Convergence a line through the long axis of the blood stain n Where they intersect is the origin of the blood n How could we do it in 3 -D?

Calculating Angle of Impact Sine of angle = width/length OR… sin-1(width/length) = angle

Other types of spatters n Satellite – Blood dripping into blood n High velocity – The higher the velocity, the smaller the droplets – Gunshots produce a “mist” pattern § Forward (past the exit wound) § Back (towards the gun) Path of bullet n Note where spatters aren’t…
- Slides: 31